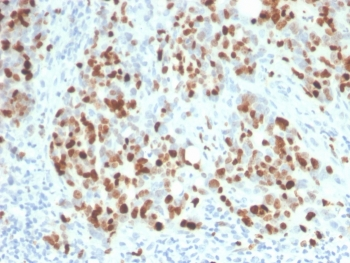
Recombinant Ki67 Antibody

You have no items in your shopping cart.
- Ki-67 Rabbit Polyclonal Antibody [orb500812]Featured

FC, ICC
Human
Human
Rabbit
Polyclonal
Unconjugated
50 μl, 100 μl, 200 μl - Ki-67 Mouse Monoclonal Antibody [orb500706]Featured

FC
Human
Mouse
Mouse
Monoclonal
Unconjugated
200 μl, 50 μl, 100 μl - Ki67 Antibody [orb515211]Featured

IF, IHC, WB
Human
Rabbit
Polyclonal
Unconjugated
50 μl, 30 μl, 100 μl, 200 μl